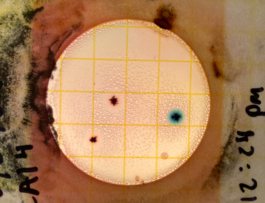
recolectivodeirrealidad.mx

********
23 de octubre de 2022
Todo el fin de semana ha estado despejado. Aprovechamos para ir a nadar un rato por la tarde, ahí donde terminan las últimas casas del pueblo, por ahí donde queda el pucté ese gigante que se acuesta sobre el agua, con sus bromelias y cactáceas enredadas. Lavita y Perri se quedaron tomando la brisa encima del muelle abandonado mientras nos miraban crolear de lado a lado en googles. El agua estaba bastante calmada y no había tantos mosquitos.
********
24 de octubre de 2022
Hoy después de la comida pasé a buscar a Fili con la moto por su casa. Chiquitita me salió a saludar en la entrada, con esos colmillos prognatos de jabalí tan chistosos que tiene. Fili agarró su Italika y ya nos lanzamos para el terreno ahí donde está chambeando, ahí donde chapéa y está cuidando. Fuimos porque según me contó que ya le avisaron al dueño que las obras del tren, al final resulta que si, le van a pasar encima por donde tiene plantado. Entonces el dueño le pidió que antes de que rasparan todo eso, fuera a cortar un cedro viejo que tiene ahí y se lo trajera.
Cuando llegamos Fili me enseñó ese cedro y más adelantito varios árboles de limón, naranja agria, mandarina y alguno de aguacate, que también son parte del terreno y que según él también les van a pasar encima. Bajamos unas cuantas mandarinas que estaban ya maduras y me regaló unas que guardé aquí en mi morral. Después Fili me guió por un caminito dentro del terreno, entre palmas y más palmas de coco, hasta aparecer en un lugar despejado, que se veía que habían chapeado, en el que se intuía una especie de montículo de piedras apiladas. A su alrededor había una malla naranja, de esas como de obra, perforada, delimitando un cuadrado y en un árbol de la esquina, una cinta rosa anudada con unos números del INAH señalizando el lugar.
Fili me contó que por los alrededores de ese lugar, entre las piedras amontonadas, había encontrado algunos pedazitos de barro hace ya algún tiempo. Rastreando brevemente ese perímetro no vimos nada en particular. Seguimos caminando y salimos del terreno hacia la parte raspada y aplanada de las obras del tren, todo esto yo sin despegar los ojos del suelo. Al cruzar las obras donde tumbaron el monte, llegamos al camino antiguo de la CFE, por donde pasan las torres de alta tensión. En ese punto, al lado de uno de esos pilares, de repente, quién sabe si por el deslave de las lluvias de la semana pasada o por que, empezamos a encontrar de poco en poco fragmentos y más fragmentos cerámicos: en pedazos rotos, rallados unos, rojos otros, oscuros, de barro más claro, cada 3 o 4 metros, algunos con borde, otros que se confundían con la tierra negra.
Estuvo muy loco este encuentro. Seguimos andando un ratito más, recorriendo ese camino en dirección a la Laguna Conejo, y guardamos algunos de esos pedazos aquí en el morral. Ya en algún punto, el camino se volvió muy embarrado y frondoso, y en vez de adentrarnos mas hacia el humedal, viendo también que los mosquitos se ponían más recios, decidimos dar media vuelta. Ya de regreso hacia las motos, yo aún sin dejar de mirar hacia bajo por todo ese tiempo, en un charco al lado del camino aparecieron unas huellas hundidas en el fango. Grandes, profundas, como del tamaño de las flops de Fili. Sin duda reconocimos que eran de tapir. Sin duda estuvieron muy locos todos estos encuentros.




********
25 de Octubre de 2023
Día de monitoreo de la Laguna con Agua Clara. Salimos bien temprano de Buenavista rumbo a Bacalar. Quedamos de encontrarnos con Mel, Naomi y los demás a la altura de las villas Ecotucán. Ahí estaba Steve, con su lancha al más puro estilo “Miami Vice”, listo para llevarnos a recolectar y a muestrear desde la zona norte, en Pedro Antonio Santos, hasta la zona sur de Los Rápidos, casi en Xul-ha. En total casi unos 100 km de recorrido con más de 20 puntos de monitoreo, en los cuales se toman muestras y se miden parámetros de calidad del agua como la temperatura, pH, conductividad, turbidez, oxígeno disuelto, etc.
Partimos en la lancha y sin detenernos rumbo al poblado de Pedro Antonio Santos, conocido por la venta de piña miel y sus derivados como jugo de piña, panqué de piña etc, y ahí tomamos la primera muestra. Bajando rumbo sur el siguiente punto de muestreo, a unos 4km, fue pasando el rancho ganadero San Martín, justo en el punto de desembocadura que conecta la Laguna de Bacalar con la Laguna Conejo y Teresita de Buenavista.
Ese punto es uno de los más importantes del monitoreo ya que en 2020, después de la temporada de lluvias y del paso de la tormenta tropical Cristóbal, fue por donde entraron gran parte de los sedimentos que cambiaron la coloración de la Laguna, pasando de los siete tonos sublimes de azul al café y al verde embarrado. Este hecho, en pleno contexto pandémico, fue uno de los primeros signos de alerta que indicaban que algo no estaba del todo bien. Así la deforestación de una proporción cada vez mayor de la selva y mangle por parte de la agricultura intensiva y el crecimiento urbano, no permitió que se filtrara adecuadamente todo ese cauce de agua superficial. Esto evidenció por un lado la interconectividad y los flujos norte-sur, sur-norte de la Laguna, y a la vez marcó un punto de inflexión entre lo que se conoce como un sistema oligotrófico, con niveles muy bajos de nutrientes, a un sistema eutrófico, con exceso de nutrientes de nitrógeno y fósforo, en este caso provenientes de los fertilizantes agroquímicos y de las escorrentías domésticas. Ese año también sucedió que hubo una mortandad masiva de caracol chivita en esta región norte de la Laguna, como de un 30%, eso no salió tanto en los medios pero resulta que investigadores de Ecosur también detectaron glifosato.
El siguiente punto de monitoreo, a otros 4km al sur, es el punto favorito de Mel, al que ella llama coloquialmente como “el Dedo”; uno de los pocos lugares no perturbados del litoral poniente de la Laguna. Ahí se forma una especie de bahía estrecha en la que sientes que la selva te abraza y el agua, de un color menta, turquesa, cian, celeste, cerúleo imposible, se intercambia en espejo con el cielo. Después de esa recolección, obviamente, nos concedimos ahí unos minutos de goce y disfrute. Nadamos en silencio, creo que sobrepasados por una sensación tácita de asombro, respeto y admiración ante tanta belleza inundando nuestros ojos.
Proseguimos con el monitoreo rumbo sur hacia Buenavista, ahí nos detuvimos en frente del balneario ejidal y después en los esteros de enfrente que se comunican con la Laguna Chile Verde. Seguimos bajando hasta Xtomok, un antiguo campamento maderero que desde los noventas forma parte del lugar de adiestramiento del Cuerpo de Fuerzas Especiales del Ejército Mexicano. Pasando de enfrente, en un islote pequeño del otro lado se aprecian cruces, banderines sobre palos, cascos y alguna que otra prenda de vestir, que según cuentan es de quienes perdieron la vida durante los entrenos. Una liturgia militar enigmática en medio de este lugar.
Ya llegando a Bacalar, recolectamos varias muestras en diferentes puntos a lo largo del pueblo, entre los que destacan los del cárcamo en el muelle público de la 36, un lugar para el almacenamiento y tratado de aguas negras que año tras año en la mayor parte de los monitoreos sale positivo en e.Coli. Después de pasar por el canal de Los Piratas, Cenote Negro, Cocalitos y Sac-Ha, hicimos el último muestreo en la entrada de Los Rápidos. En este lugar se estrecha la Laguna de Bacalar a lo largo de unos 5km hasta abrirse de nuevo en la Laguna de Xul-ha. Debido a este estrechamiento el flujo de agua es mayor y eso se piensa que promueve la formación de estromatolitos de mayor tamaño.
Rodeados de estas megaestructuras de calcio y vida ancestral, nos dimos un último baño a modo de celebración del fin del monitoreo. Media vuelta y ya de regreso, el motor de la lancha de Steve ocurrentemente empezó a fallar y tuvimos que hacer los últimos 15 km casi al ralentí. Llegamos cansados, insolados y anocheciendo al muelle y aún tuvimos que ir hasta las oficinas a trasladar las muestras para preservar y poder hacer el resto de análisis los días siguientes. Finalmente llegamos rendidos y agotados a la casa pero sintiéndonos a la vez orgullosos y afortunados de haber podido participar, conocer y aprender de esta experiencia irrepetible de “ciencia ciudadana”.